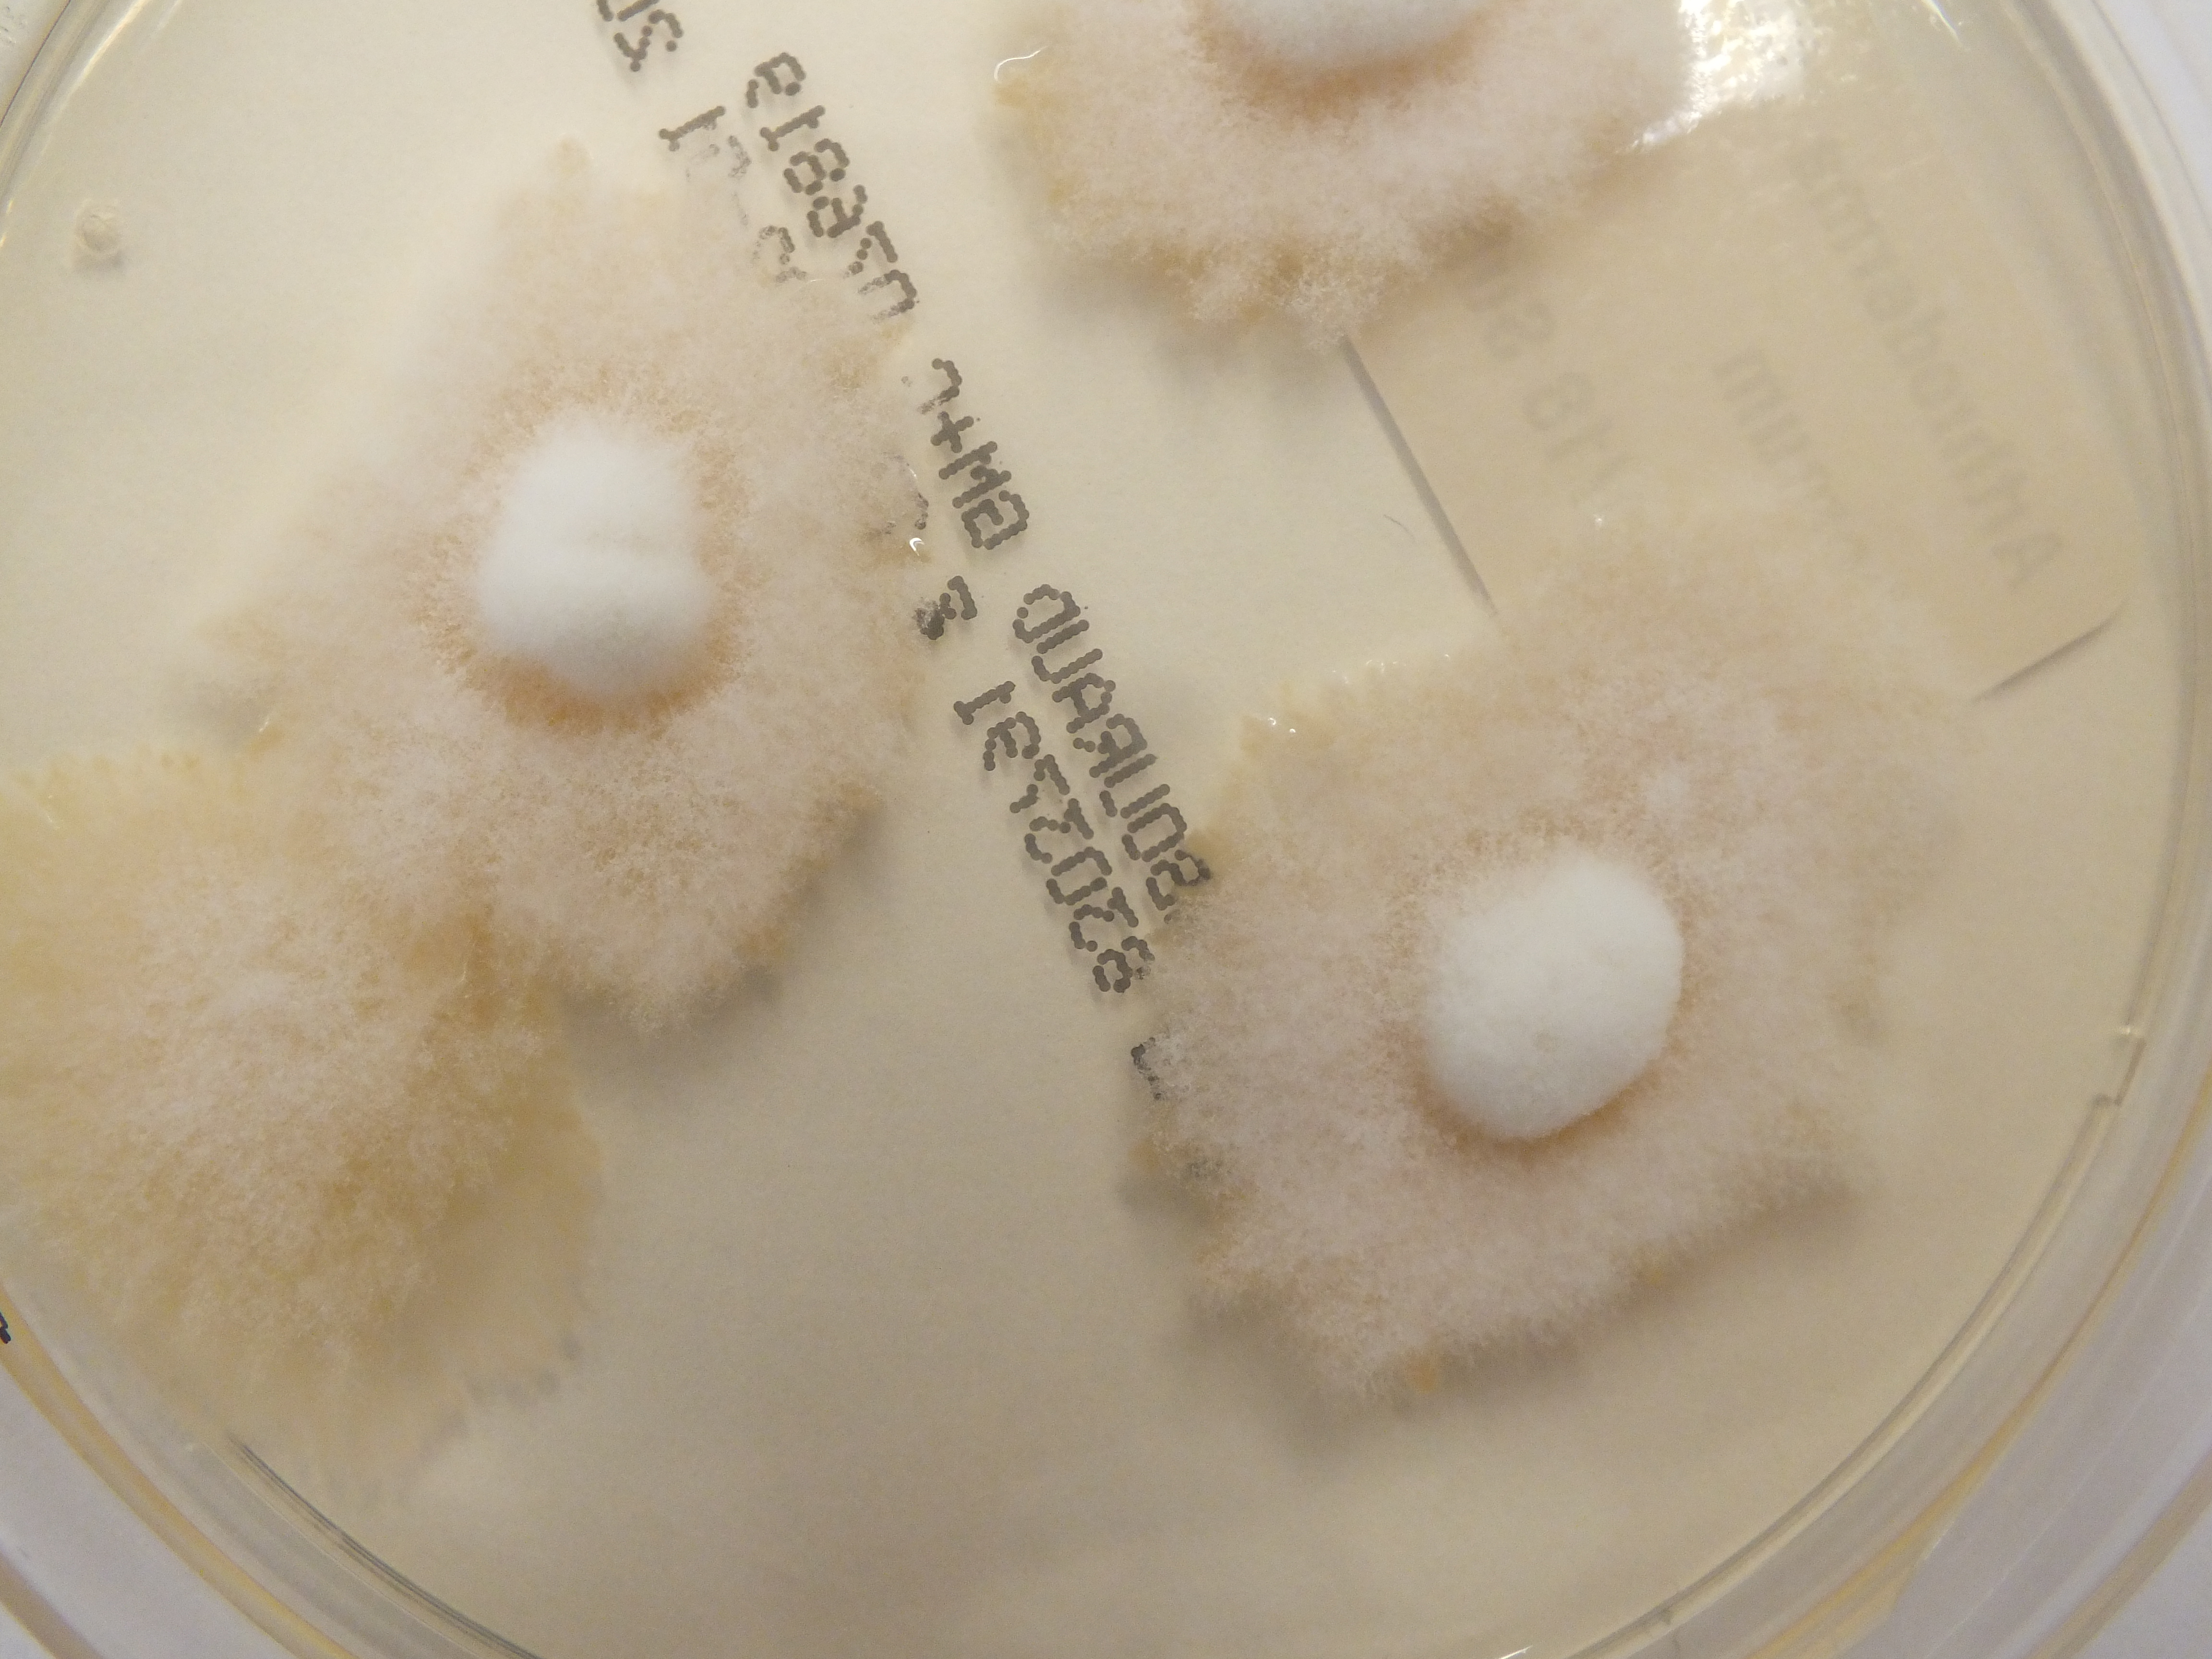
None
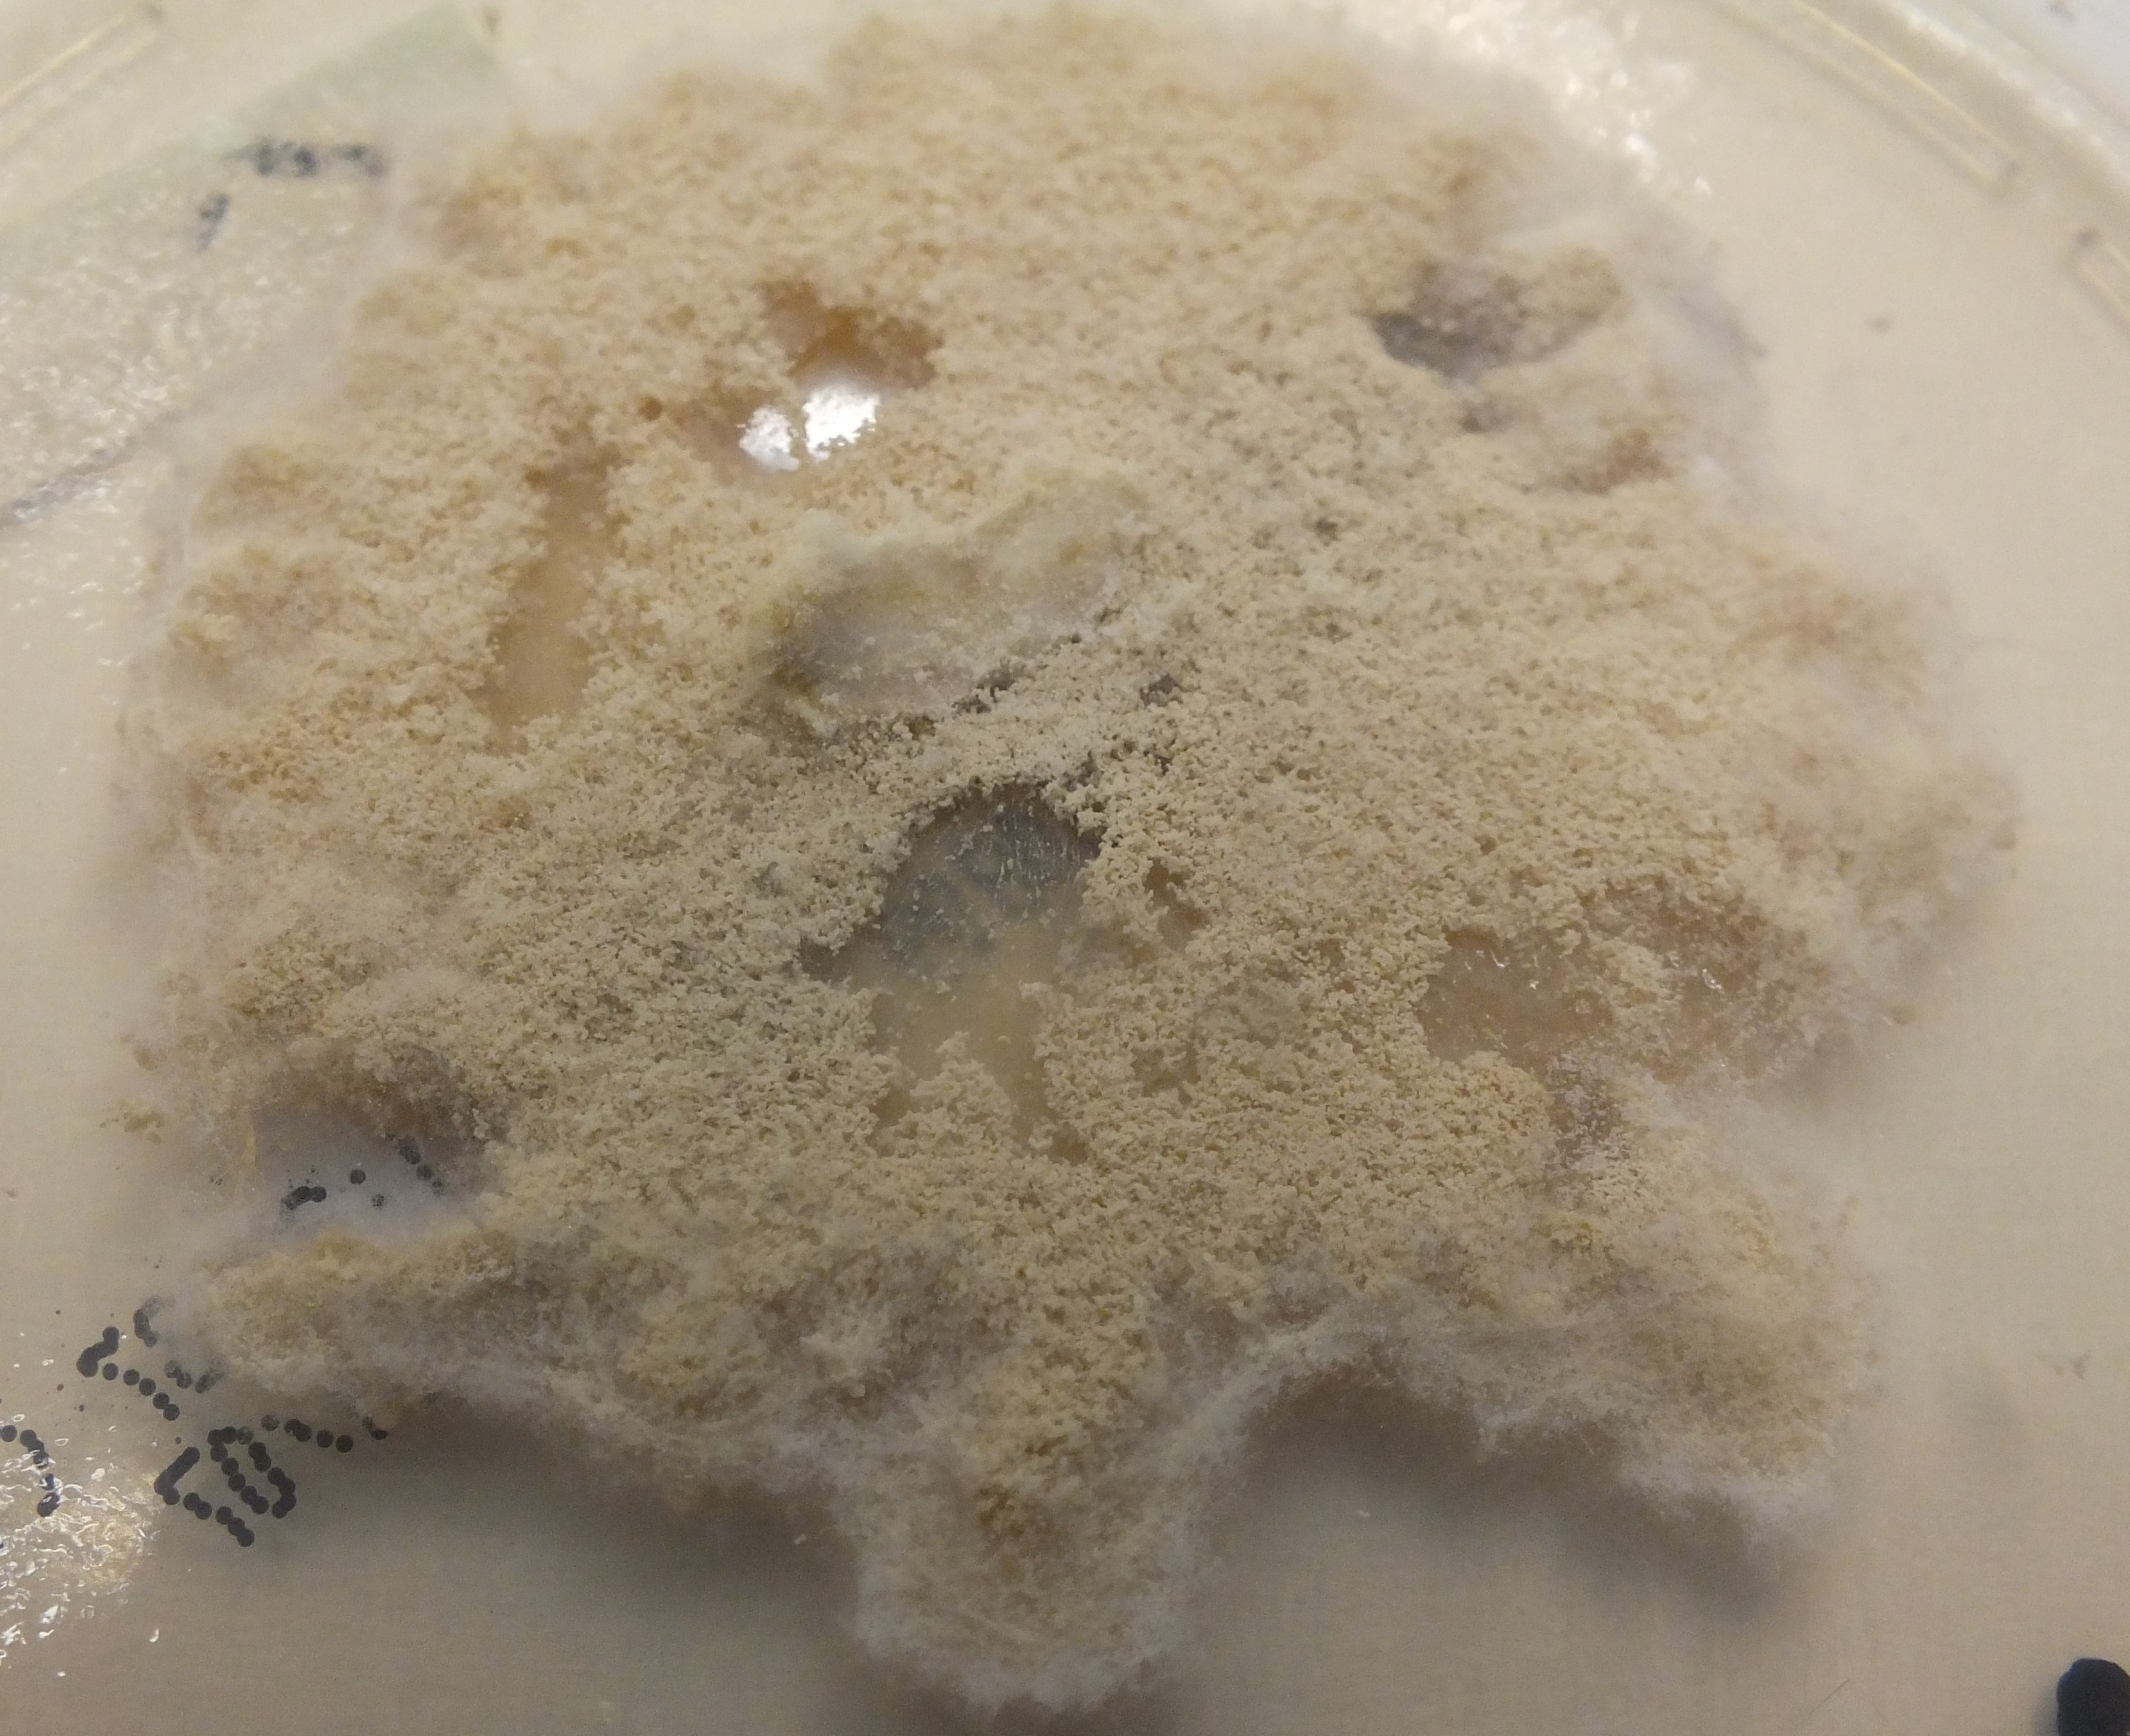
None
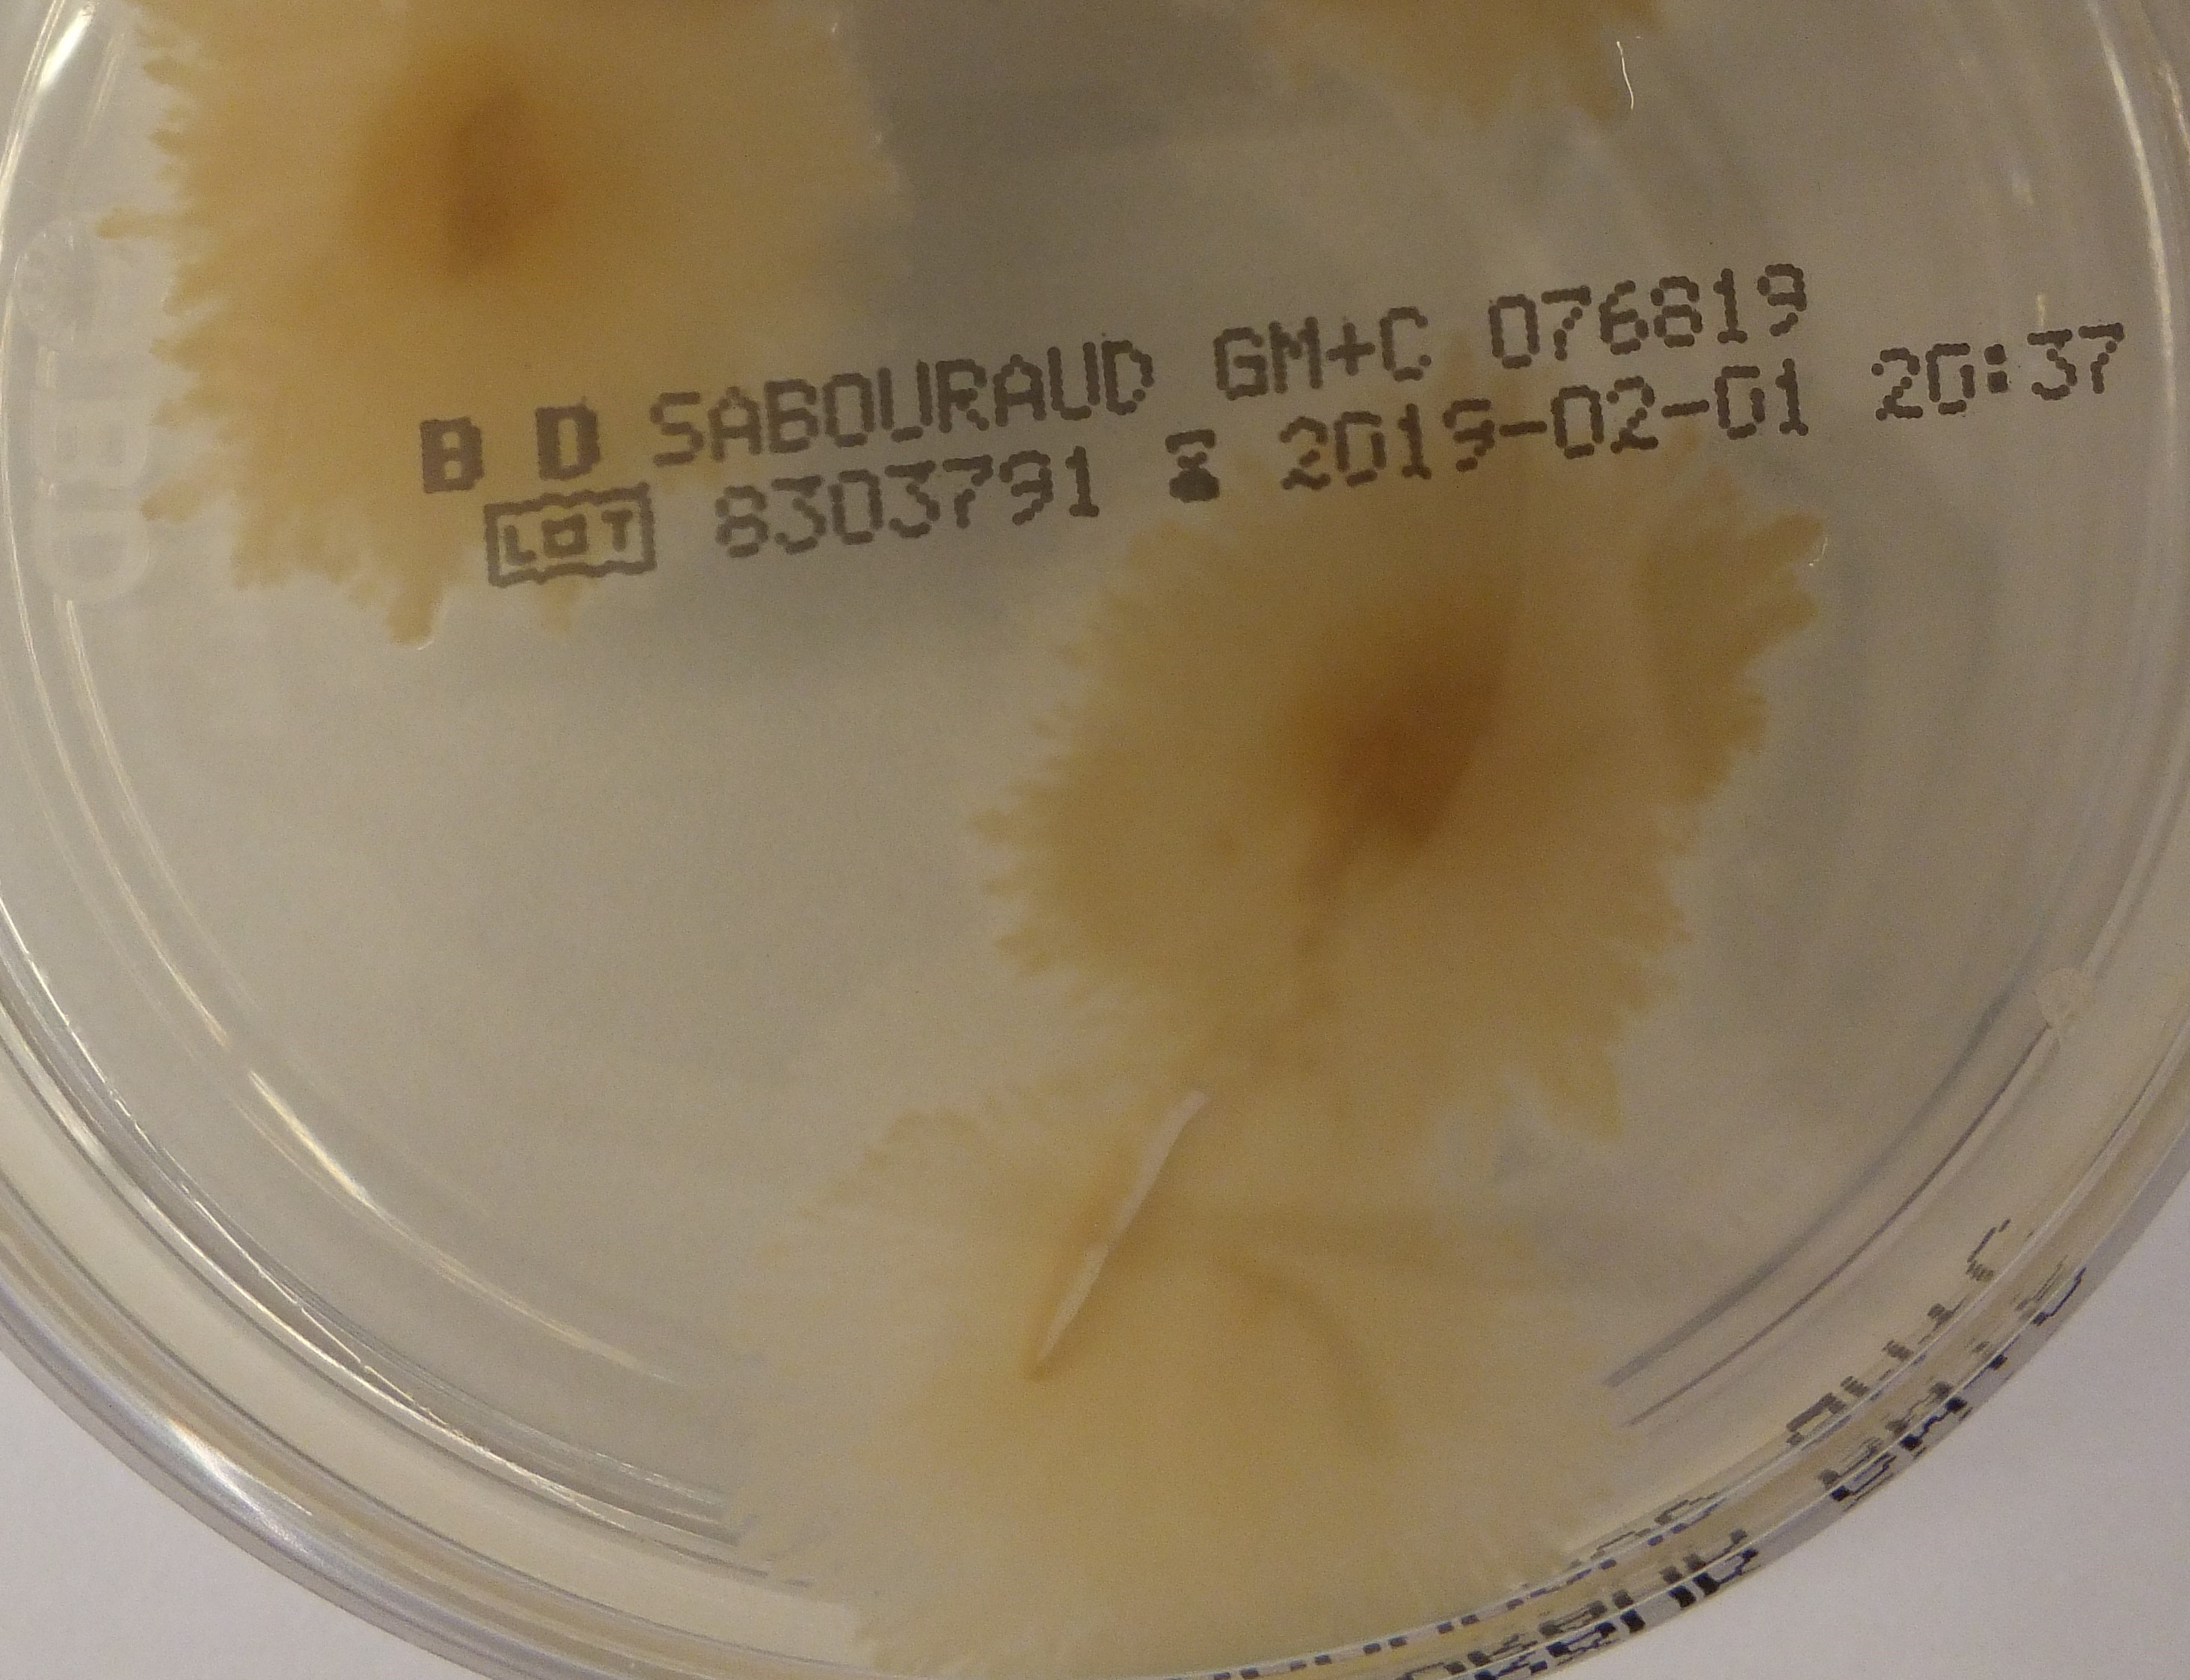
None
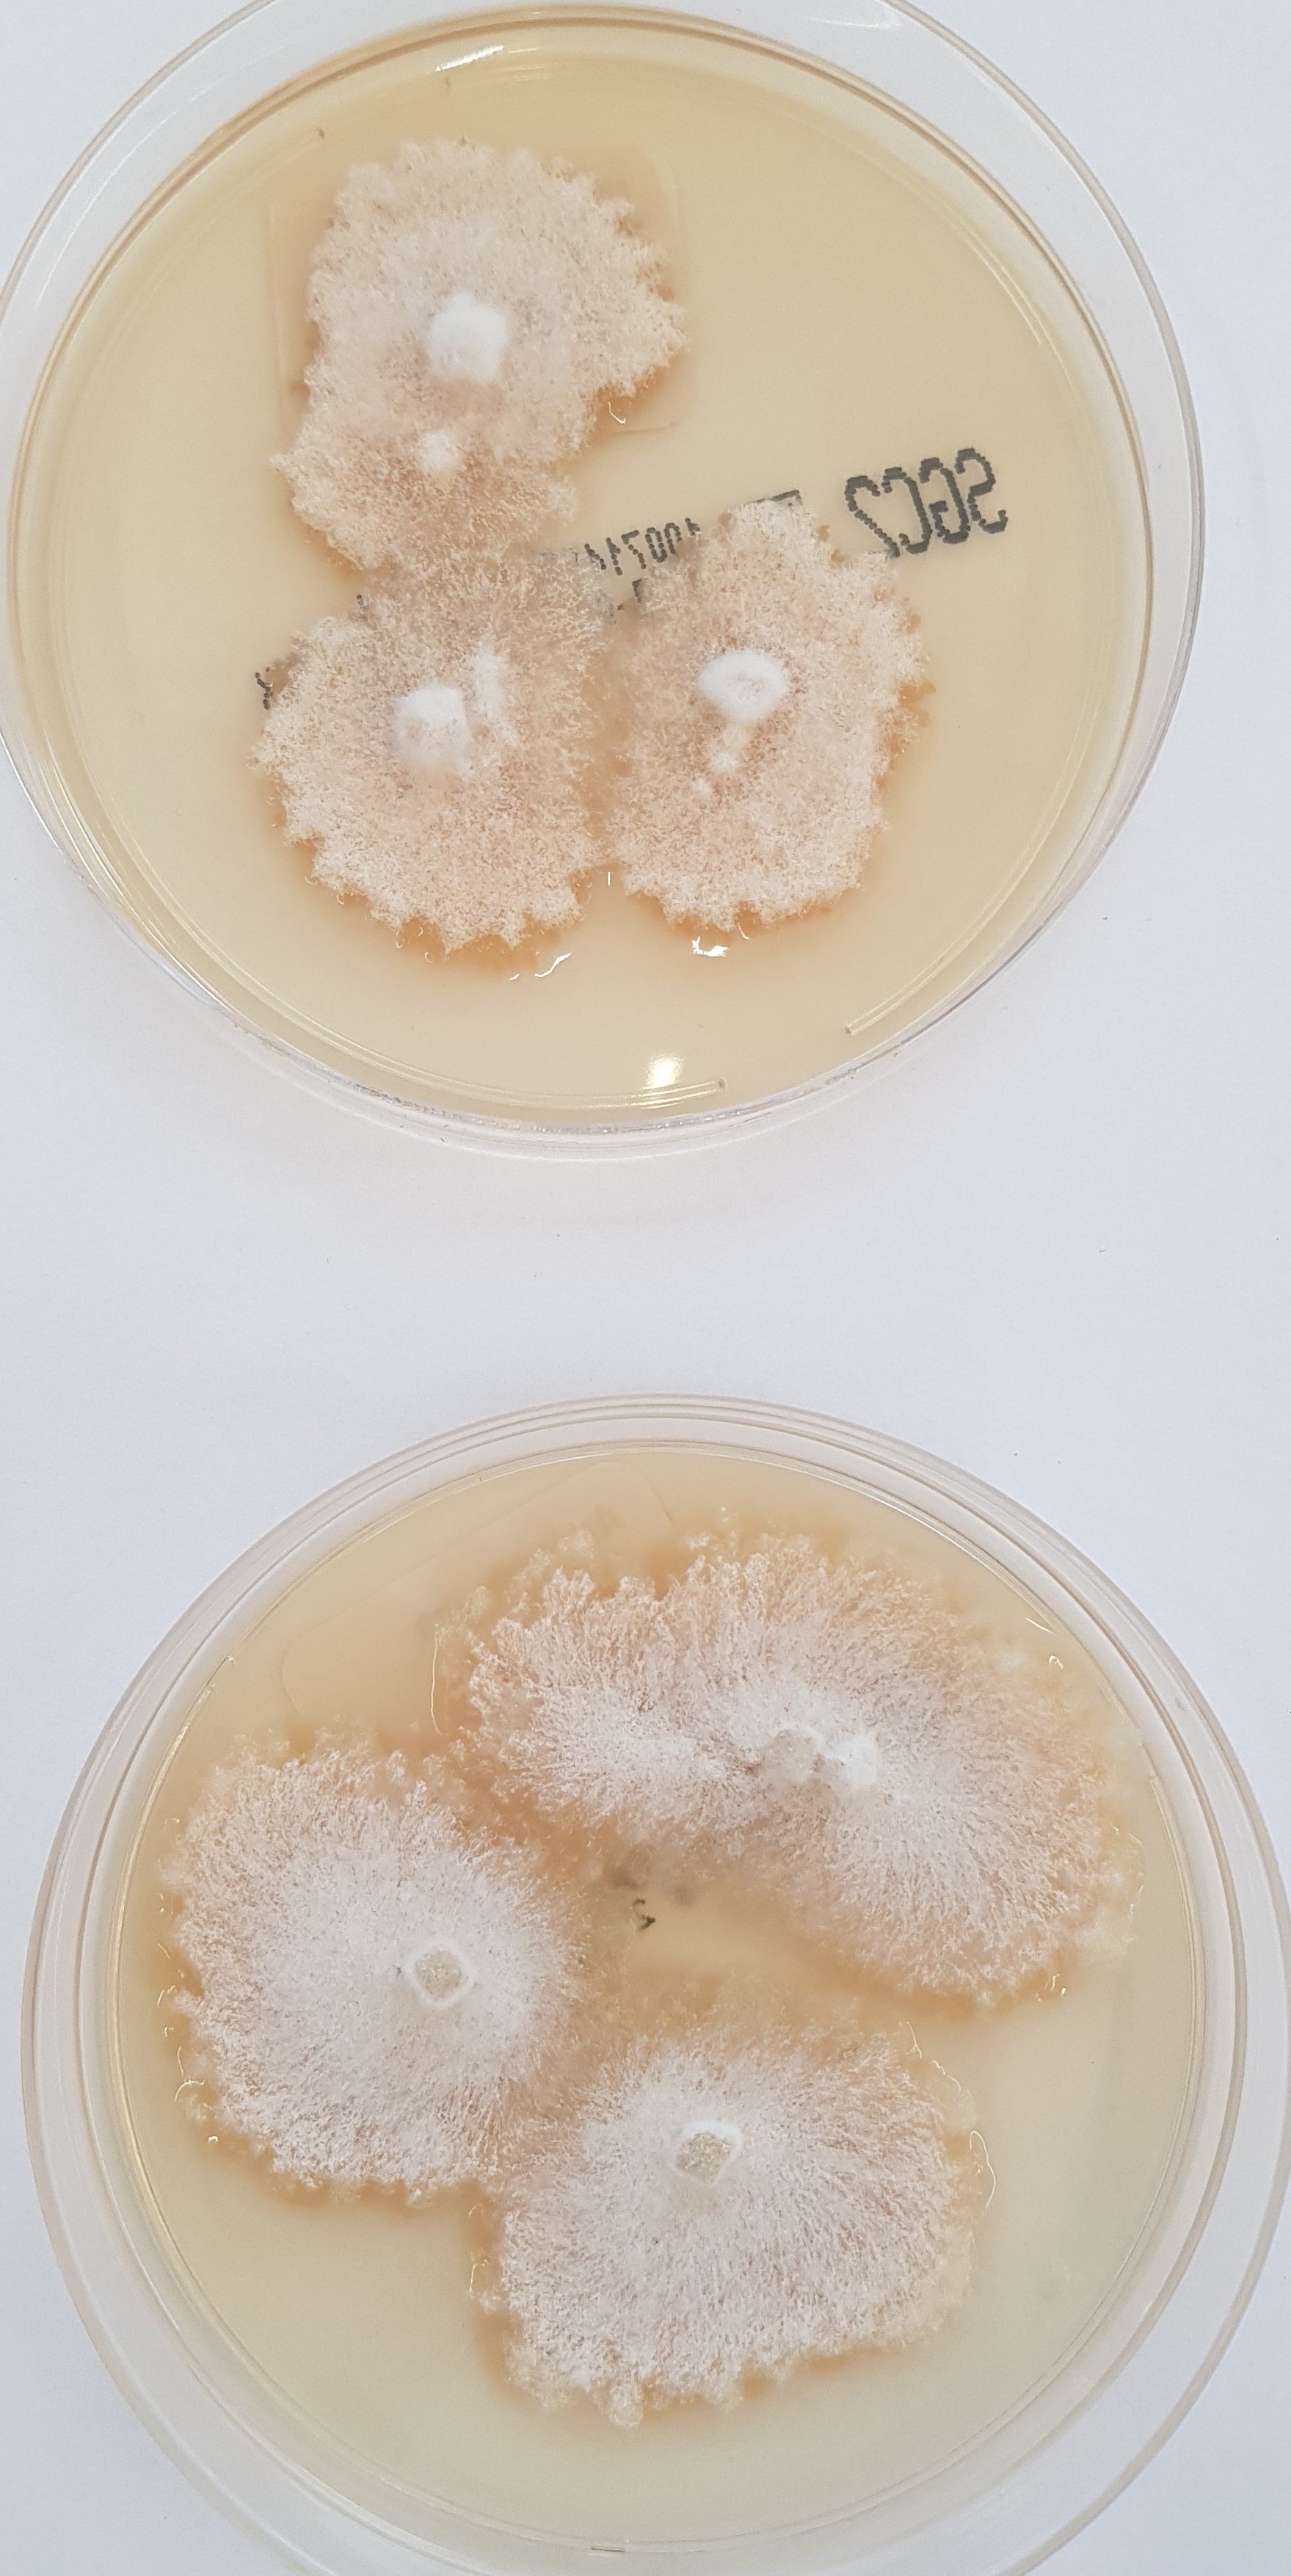
None
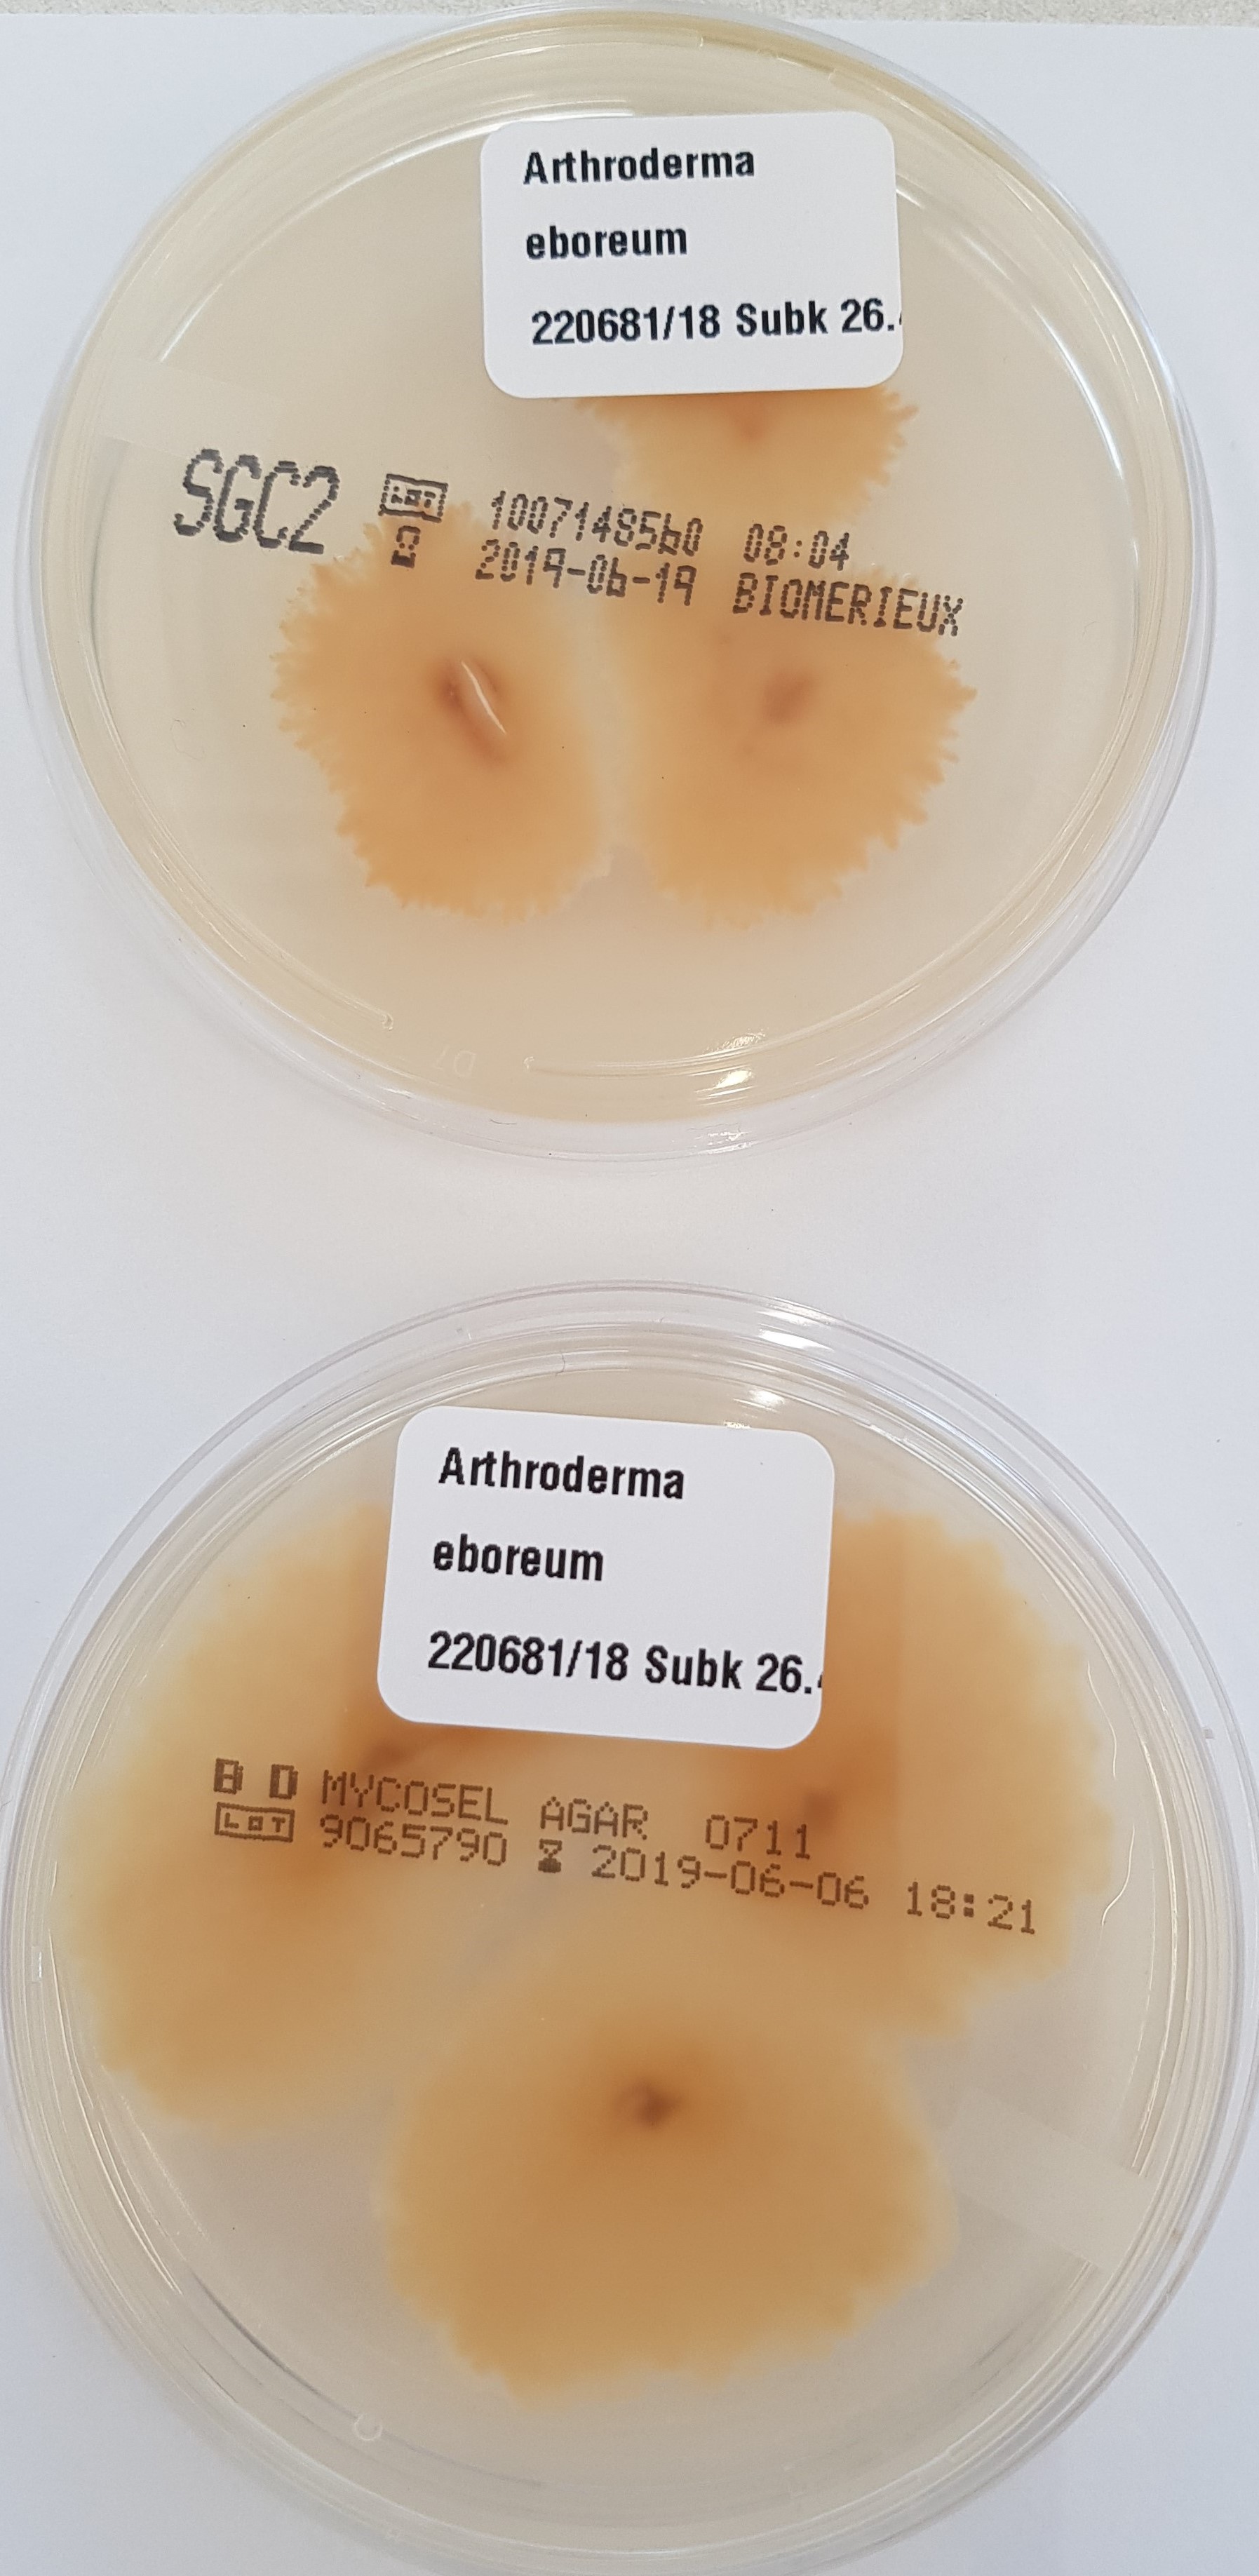
None
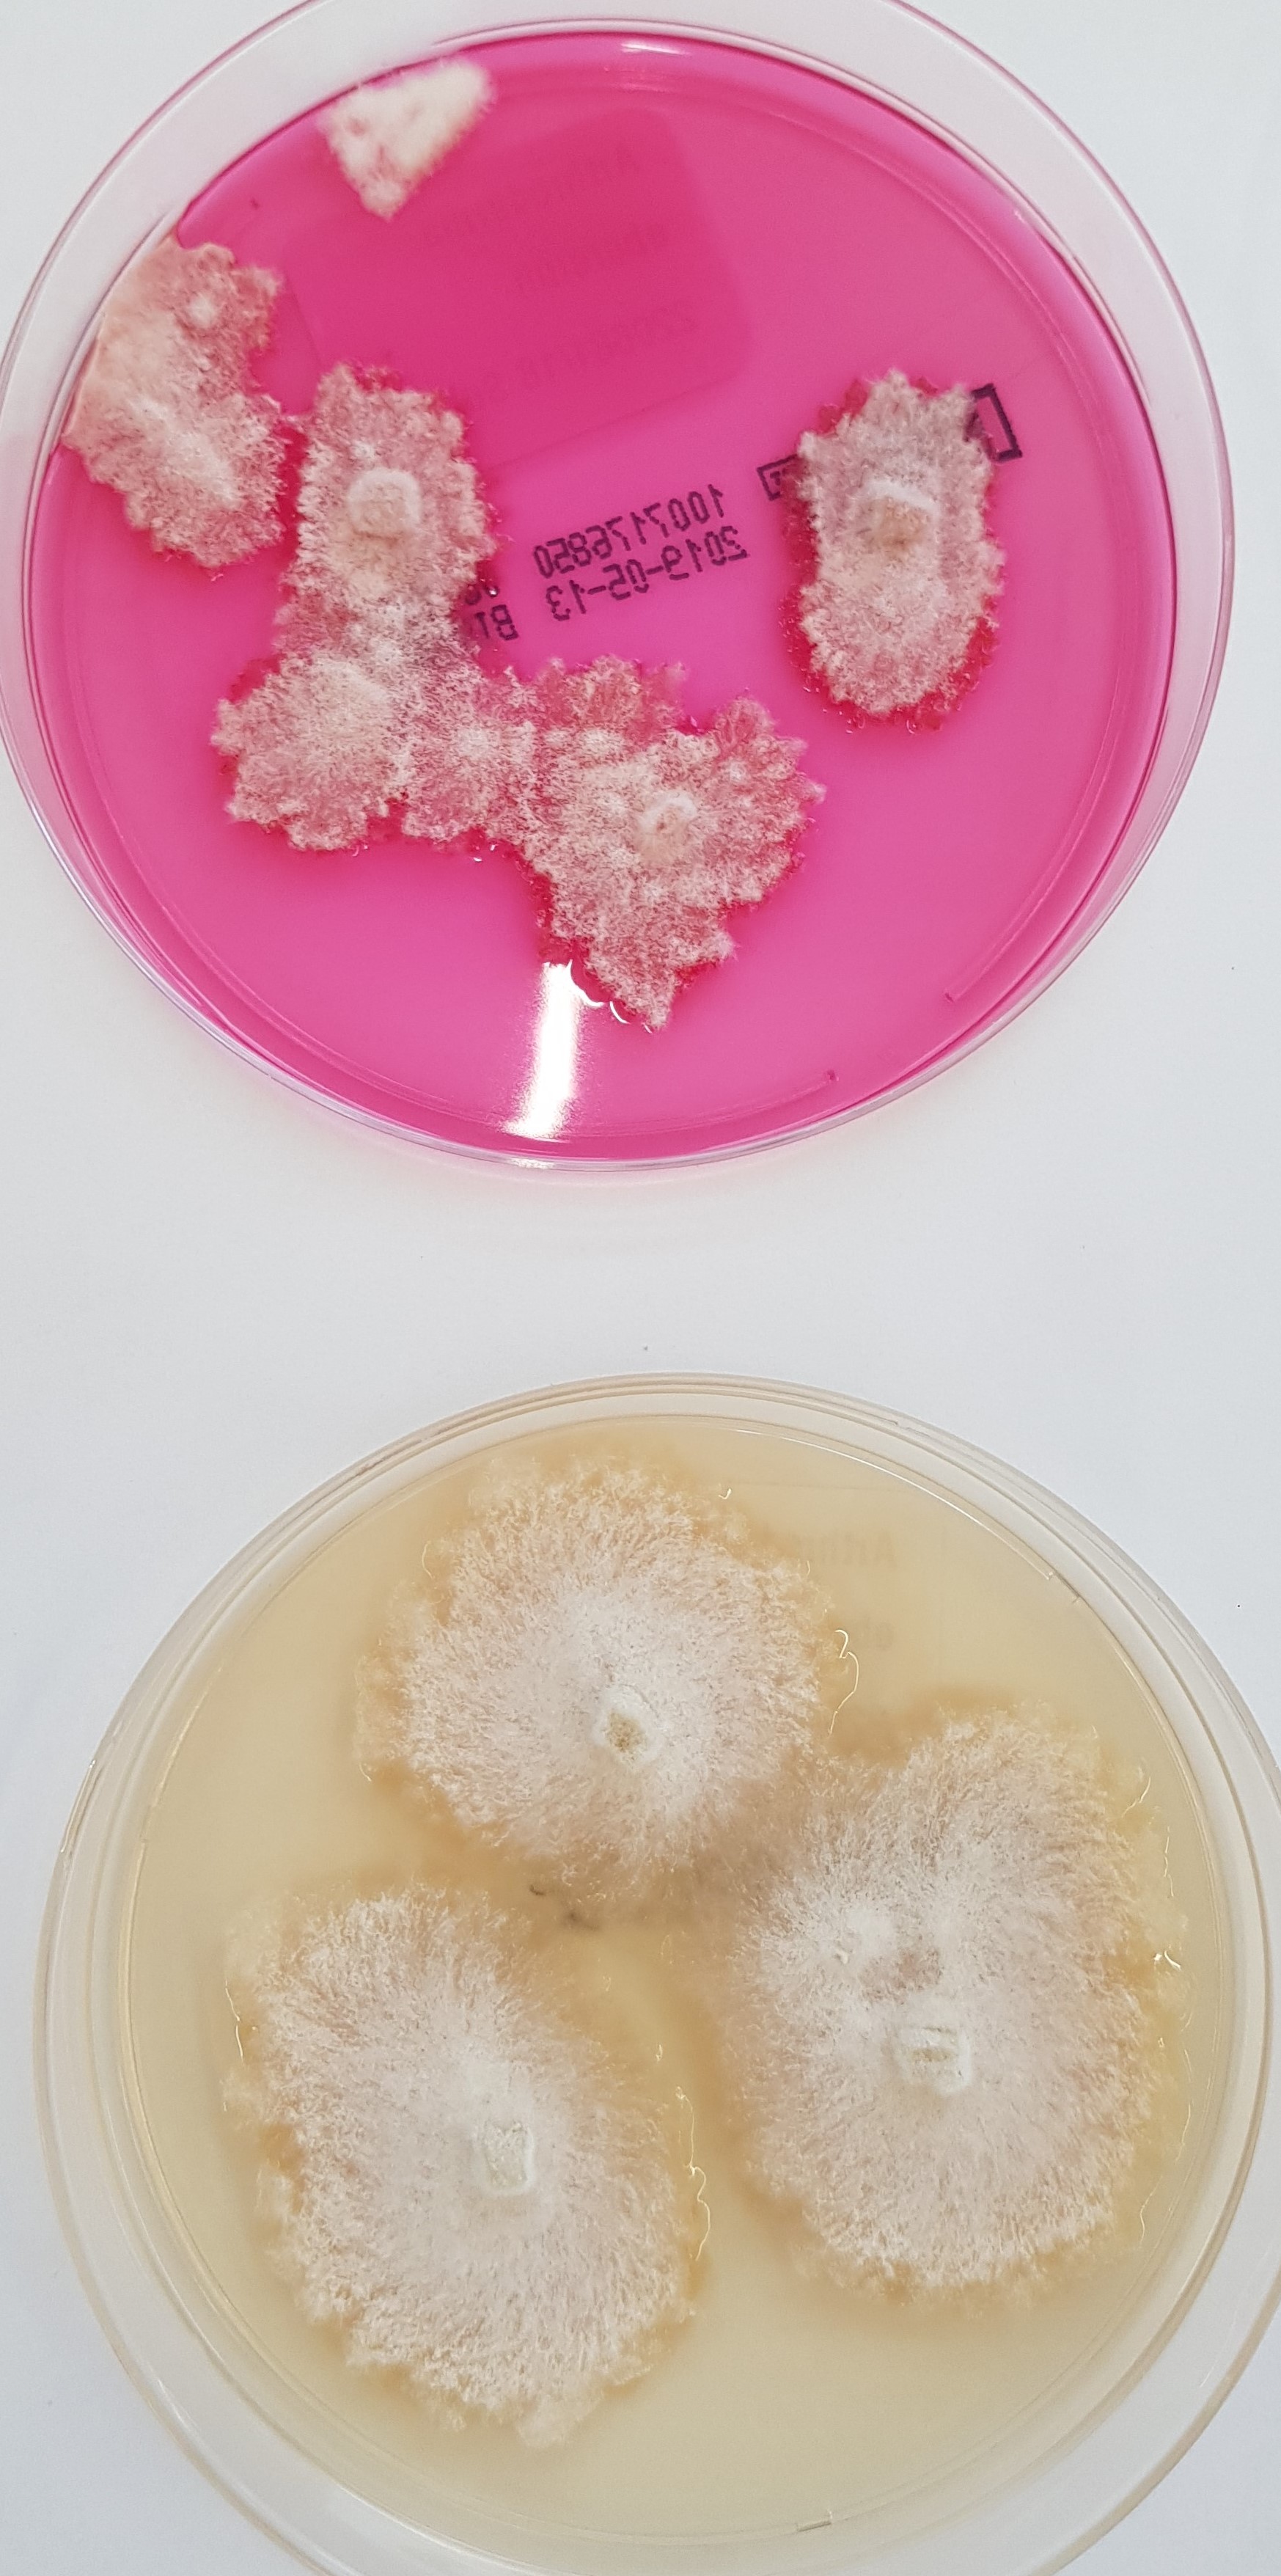
None
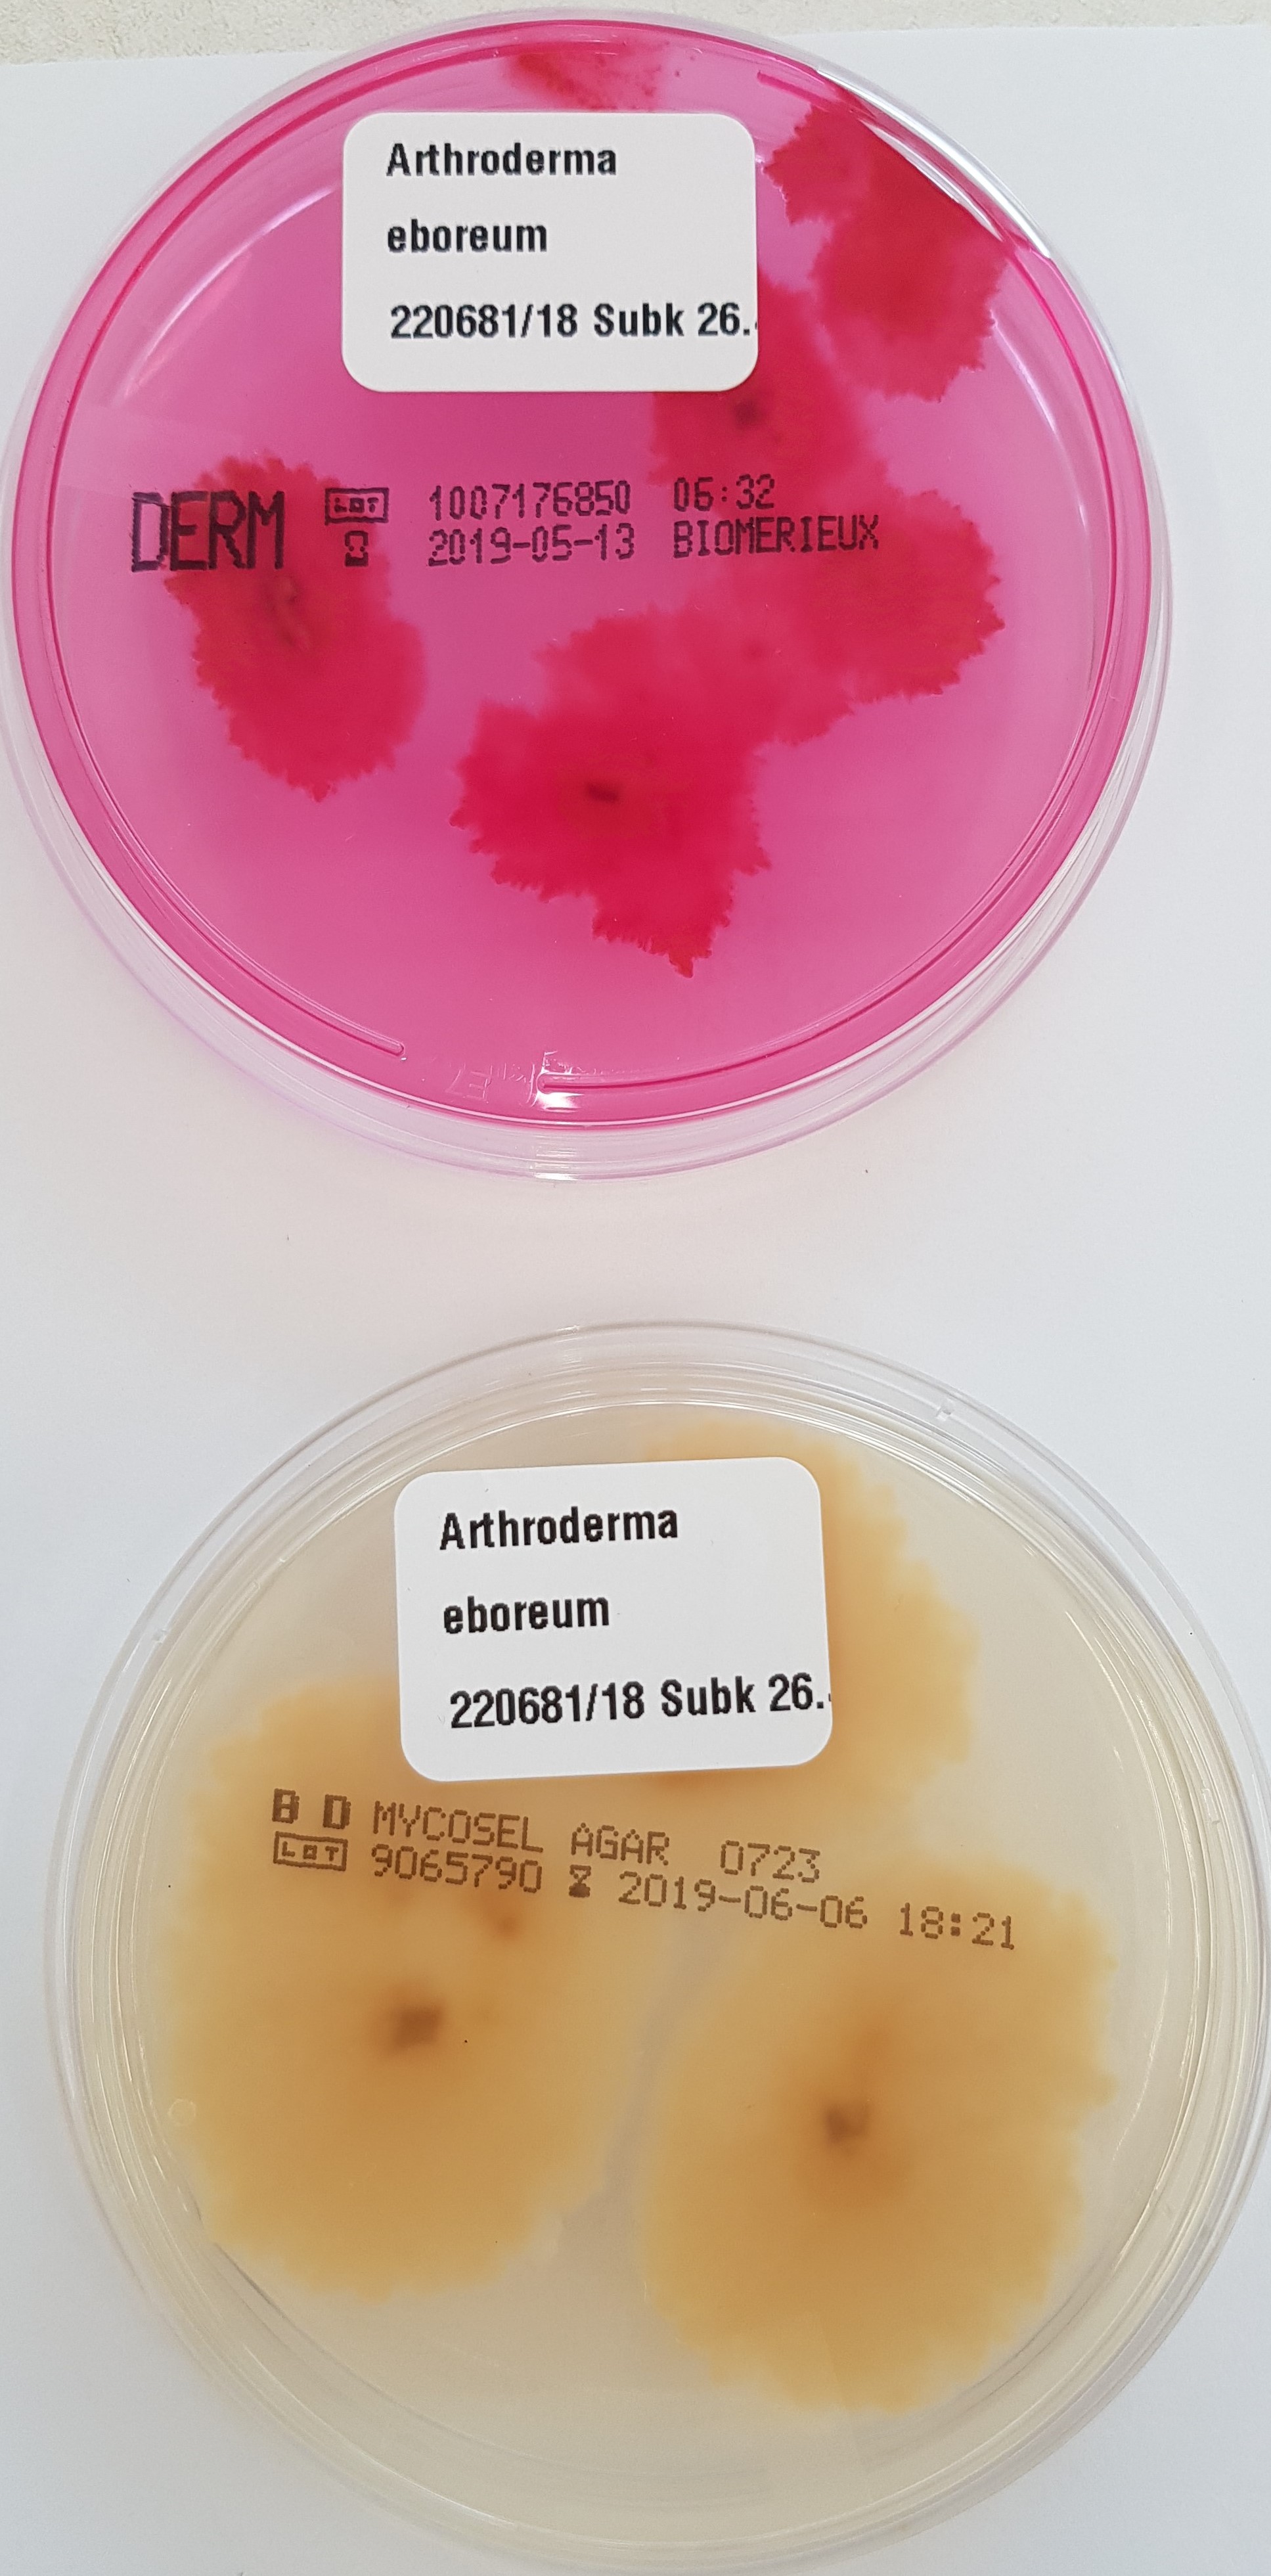
None

Arthroderma eboreum (Brasch & Gräser 2005) Gräser & de Hoog 2017
Arthroderma (A.) eboreum (früher Trichophyton eboreum, Synonym Arthroderma olidum Campbell et al.) ist ein geophiler und wahrscheinlich auch zoophiler Dermatophyt, der weltweit in der Umwelt vorkommt. Der Dermatophyt wurde bislang nur sehr selten von Menschen isoliert, wenn, dann allenfalls mit milden klinischen Manifestationen einer Dermatomykose oder wahrscheinlich sogar eher lediglich als saprophytäre Kontamination.